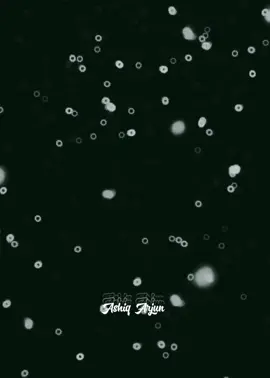
#CapCut

_will.grau
Region: BR
Sunday 03 November 2024 19:28:09 GMT
10917062
1277059
6394
89729
Music
Download
Comments
luiz :
“NÃO O FEIJÃO NÃO!”
2024-11-04 03:08:37
108547
Duke💵 :
Mlk sabe oq da valor
2024-11-04 13:04:11
40855
notificaçãobr :
a cara dele
2025-04-24 20:21:16
0
Eusiilva :
Quase infartou o Lorenzo kkk
2024-11-04 00:33:07
5624
Teodosiio_ :
o mlk entregou o cllr na maior facilidade vei kkkkkkkkkkkkkkkkk
2024-11-04 14:30:58
9897
clarissa motta :
QUE FOFO ELE ENTREGANDO O CELULAR P NAO PEGAR O CACHORRO
2024-11-04 04:15:04
68700
Jandair Bujões de gás :
"O feijão não"
2024-11-04 11:17:54
41537
Luiz💯ex :
Não o feijão não
2024-11-04 04:20:56
1678
João Marcos Diniz Ca :
será que ele sabe que mora no Brasil?
2025-01-24 14:37:43
0
Adrianohornet :
brincadeira sem graça viu💀
2024-11-04 10:24:28
621
fabioluft92 :
q susto no Enzo
2024-11-04 13:30:47
1709
Forastieri🔱 :
“PELO CACHORRO EU DO MINHA VIDA” KKKKKKKKKKKKKK
2024-11-04 03:22:49
8032
AD. SIMPLÍCIO 👑 :
Enzo disse "meu filho não", "sou pai de pet" 🤣🤣🤣
2024-11-04 13:28:13
60
Uly Costa :
quando pediram o cachorro ele deu logo o celular, " não não o cachorro não " 🥰 aí sabe diferenciar o que tem preço e o que tem "valor". Bom menino
2024-11-04 16:36:27
846
lay🙂↕️ :
“passa o telefone ai” “pq?” KKKKKKKKKKKKKK
2024-11-04 21:42:36
7704
amber :
tadinho kkkkkkkkkkk "o cachorro não "
2024-11-04 18:07:06
1423
alexsandrosantos7803 :
é isso aí prioridades, desistiu do celular na hora 🫡 soldado promovido
2024-11-04 01:09:49
4943
fernando :
mis respeto prefiero al perro antes q su iPhone
2024-11-04 18:23:32
1482
Eduardo :
kkkk oxi ele negou mais o cachorro doque o celular
2024-11-04 16:28:01
5530
sʟᴀsʜ.ᴠᴘ💤 :
lembrei do reh o "O FEIJÃO NÃO"KKKKKKKKKKKKKKKKKKKKKKKKKKKKKKKKKKKKKKKKKK
2024-11-04 15:29:24
33186
user20041210570 :
que cara fofo kkkkkkkkk queria ser amigo dele
2024-11-04 06:55:37
862
nick :
ele perguntando o pq de passar p celular KKKKKKKK EU TO ME MIJANDO
2024-11-04 15:09:33
4868
1bela_1 :
Ele entregando o celular e pegando de volta ALAKAKAKAKAKKKAKKKKAKAKAKAKAKAKAKAKAKAKAKAKA EU TO CHORANDO
2024-11-04 04:58:17
1845
carvalho. :
geral zoando o mlk mas se tivesse no lugar desse menó 🤣
2024-11-04 04:18:10
728
felipe :
Coitado do Enzo 🤣🤣
2024-11-04 15:36:21
16
To see more videos from user @_willgrau, please go to the Tikwm
homepage.